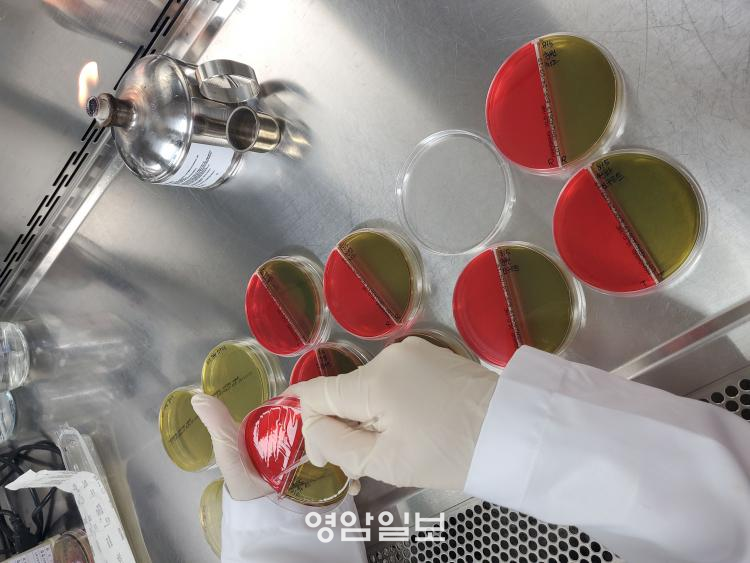

|
¼ö°Å°Ë»ç ´ë»óÀº ¹«ÀÛÀ§·Î ¼±Á¤µÈ Ãà»ê¹° Á¦Á¶¡¤ÆÇ¸Å¾÷¼Ò 27°³¼Ò·Î, µ¿¹°À§»ý½ÃÇè¼Ò°¡ Á÷Á¢ ¼ö°ÅÇØ °Ë»çÇÑ´Ù. °Ë»ç Ç׸ñÀº »ì¸ð³Ú¶ó, ´ëÀå±Õ, ¸®½ºÅ׸®¾Æ µî ÁÖ¿ä ½ÄÁßµ¶±Õ 5Á¾°ú º¸Á¸·á¡¤Å¸¸£»ö¼Ò µî ½Äǰ ÷°¡¹°ÀÌ´Ù.
* ½ÄÁßµ¶±Õ 5Á¾ : »ì¸ð³Ú¶ó, ¹Ù½Ç·¯½º, ¸®½ºÅ׸®¾Æ¸ð³ë»çÀÌÅäÁ¦³×½º, Ȳ»öÆ÷µµ»ó±¸±Õ, ÀåÃâÇ÷¼º´ëÀå±Õ
* ½Äǰ÷°¡¹° : º¸Á¸·á(ºÎÆÐ¡¤º¯Áú ¹æÁö), ½Ä¿ë Ÿ¸£»ö¼Ò(¼±¸íÇÑ ½Äǰ »ö»ó ¹ßÇö)
°Ë»ç °á°ú ºÎÀûÇÕ ÆÇÁ¤ ½Ã ½ÄǰÀǾàǰ¾ÈÀüó µî °ü°è±â°ü¿¡ ¾Ë¸®°í Á¦Á¶¡¤ÆÇ¸Å¾÷ü¿¡ ½Å¼ÓÇÏ°Ô Åëº¸ÇØ ÇØ´ç Á¦Ç° À¯ÅëÀ» Áï½Ã Â÷´ÜÇÒ °èȹÀÌ´Ù.
Á¤Áö¿µ Àü³²µµµ¿¹°À§»ý½ÃÇè¼ÒÀåÀº ¡°Ç³¿ä·Î¿î Ãß¼®À» ¸Â¾Æ µµ¹ÎÀÌ ¾È½ÉÇÏ°í µå½Ãµµ·Ï Ãà»ê½Äǰ ¾ÈÀü¼º °Ë»ç¸¦ ÁýÁß ½Ç½ÃÇϰڴ١±¸ç ¡°Ãà»ê¹° Á¦Á¶¡¤ÆÇ¸Å¾÷ °ü°èÀÚ²²¼´Â °í¿Â´Ù½ÀÇÑ ½Ã±âÀÌ´Ï Ãà»ê¹° Ãë±Þ¡¤º¸°ü ½Ã À§»ý°ü¸®¸¦´õ¿í öÀúÈ÷ ÇØ´Þ¶ó¡±°í ´çºÎÇß´Ù.
Àü³²Áö¿ª Ãà»ê¹° °Ë»ç¸¦ Ã¥ÀÓÁö°í ÀÖ´Â Àü³²µµµ¿¹°À§»ý½ÃÇè¼Ò´Â ¸Å³â ½ÄǰÀǾàǰ¾ÈÀüó°¡ ½Ç½ÃÇÏ´Â Ãà»ê¹° ½ÃÇ衤°Ë»ç ´É·Â Æò°¡¿¡¼ ¿¬¼Ó Àû°Ý±â°üÀ¸·Î ¼±Á¤µÆ´Ù. Ãà»ê¹° ÆÇ¸Å¡¤Á¦Á¶¾÷ü¸¦ ´ë»óÀ¸·Î ¿¬°£ 1¸¸ 8õ °ÇÀÇ Ãà»ê¹° ¾ÈÀü¼º °Ë»ç¸¦ Çϰí ÀÖ´Ù.
¿µ¾ÏÀϺ¸ yailbo@daum.net
2026.02.27(±Ý) 10:12